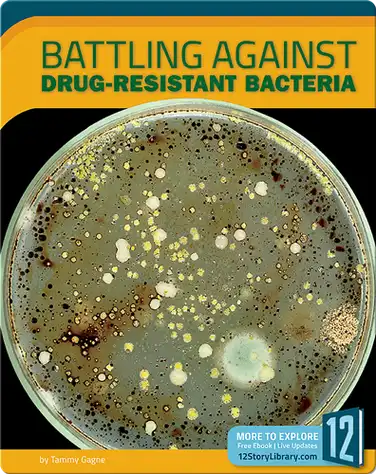
Battling Against Drug-Resistant Bacteria book

DNA
Collection Created by:Ms. Russell, an Epic Teacher
Popular Collections


Woodland/ Forest Habitat

Space & Planets

Do It Yourself

Poetry and Figurative Language

All Things Math

Ancient Civilizations

Simple Spanish Books

Weather

Electricity

Past & Present

Rocks and Minerals/Geology

Native Americans

Civil Rights

Maps and Landforms

MTSS Unit 8 Comparing and Contrasting

Middle ages

Plants and Pollinators

Seasons

Immigration

Fire Safety

Community Helpers/Economic Understanding Kindergarten

Insects

American Revolution

Human body

Graphic Novels

Ecosystems

US Government for 3rd Grade

WHAT IS EPIC
The Leading Digital Reading Platform for Kids
Built on a collection of 40,000+ popular, high-quality books from 250+ of the world’s best publishers, Epic safely fuels curiosity and reading confidence for kids 12 and under.